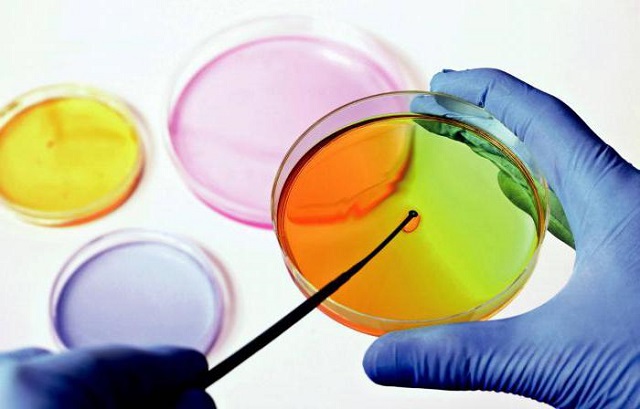
Исследование кала и мочи

Сопутствующие симптомы
Заражение бактериями или вирусами никогда не проходит без последствий, и зачастую первым признаком проблемы становится понос. При этом цвет стула может изменяться на зеленый или желтый. Например, при дизентерии водянистые выделения почти всегда имеют зеленоватый оттенок, а также можно встретить кал ярко-желтого цвета.
Какие еще признаки могут указывать на развитие серьезных вирусных инфекций?
- Лихорадочное состояние, сопровождающееся повышением температуры и обильным потоотделением.
- Бактериальная диарея часто вызывает слабость и вялость организма.
- К симптомам добавляется обезвоживание и постоянная сухость во рту.
- Боли в животе имеют схваткообразный характер и не исчезают даже после посещения туалета.
Такое состояние не проходит, пока не начнется интенсивное лечение. Симптоматика во многом зависит от того, какие именно бактерии попали в организм. Например, при сальмонеллезе могут возникнуть серьезные осложнения, такие как менингит, пневмония и гнойные поражения органов. При заражении кишечной палочкой возможны почечная недостаточность и анемия.
По мере прогрессирования инфекционной диареи появляются и новые симптомы. На острых стадиях болезни человека мучают постоянная рвота и тошнота, а также высокая температура и головные боли.
Лечение должно начинаться сразу после постановки диагноза, так как частый жидкий стул приводит к вымыванию из организма необходимых питательных веществ. На фоне нехватки микроэлементов работа всего организма усложняется, а обезвоживание может представлять угрозу для жизни пациента.
Врачи отмечают, что вирусная диарея является распространенной проблемой, особенно среди детей. Она часто вызывается ротавирусами и аденовирусами, которые передаются через загрязненные руки или пищу. Симптомы, как правило, включают частые водянистые стулы, рвоту и лихорадку. Специалисты подчеркивают важность поддержания водного баланса, так как обезвоживание может привести к серьезным последствиям. В большинстве случаев вирусная диарея проходит самостоятельно в течение нескольких дней, однако при тяжелых симптомах или уязвимых группах населения, таких как пожилые люди и маленькие дети, необходима медицинская помощь. Врачи рекомендуют избегать самолечения и обращаться за консультацией, чтобы избежать осложнений.

Диагностика у взрослых и детей
Понос при ротавирусной инфекции — это довольно распространенное явление, и поэтому установить точный диагноз в домашних условиях, основываясь только на этом симптоме, весьма затруднительно. Врачам в таких случаях необходимо провести ряд анализов, среди которых можно выделить следующие:
- иммуноферментный анализ;
- полимеразная цепная реакция;
- анализы кала и мочи.
Существует множество причин, по которым у человека может возникнуть этот тревожный симптом. Он может быть вызван активностью бактерий в организме, развитием ротавируса, а также серьезными вирусными и бактериальными инфекциями, такими как дизентерия и сальмонеллез.
Только после установления точного диагноза врач сможет назначить соответствующее лечение, так как каждая болезнь имеет свои особенности и потенциальные риски. Однако в любом случае важно восстановить водный баланс в организме. Для этого рекомендуется употреблять не менее двух литров воды в день до полного исчезновения симптомов. Также полезно использовать препарат «Регидрон», который значительно снижает риск возникновения данной проблемы. Если обезвоживание достигло третьей, наиболее опасной степени, требуется срочная госпитализация и введение раствора «Трисоль».
Активность бактерий и паразитов в организме представляет опасность, так как эти микроорганизмы выделяют токсины, которые нарушают нормальное функционирование организма. Именно поэтому на фоне таких вирусных или бактериальных заболеваний могут возникать осложнения в работе различных органов.
| Возбудитель | Симптомы | Профилактика |
|---|---|---|
| Ротавирус | Рвота, водянистая диарея, лихорадка, обезвоживание | Вакцинация, гигиена рук, избегание контакта с больными |
| Норовирус | Рвота, диарея, тошнота, спазмы в животе, лихорадка | Гигиена рук, тщательное мытье продуктов, избегание контакта с больными |
| Аденовирус | Диарея, рвота, лихорадка, респираторные симптомы | Гигиена рук, избегание контакта с больными, дезинфекция поверхностей |
| Астровирус | Диарея, рвота, лихорадка, головная боль | Гигиена рук, тщательное мытье продуктов, избегание контакта с больными |
| Энтеровирус | Диарея, рвота, лихорадка, сыпь, герпангина | Гигиена рук, избегание контакта с больными, дезинфекция поверхностей |
Инфекционная диарея у детей
Дети в возрасте пяти лет наиболее уязвимы к инфекциям, вызванным бактериями и вирусами. Понос у них может возникать по нескольким причинам:
- вирусные инфекции, передающиеся через контакт с зараженными;
- попадание патогенных микроорганизмов или бактерий через пищу и воду;
- расстройства пищеварения или колит могут стать причиной поноса;
- дети часто становятся жертвами паразитов, таких как глисты;
- также проблема может быть связана с врожденной непереносимостью определенных продуктов.
Обнаружить тревожные симптомы бывает непросто, а игнорировать их нельзя, так как заболевание требует медицинского вмешательства. Ребенок может стать вялым, у него поднимается температура, пропадает аппетит, появляются головные боли. На фоне этих симптомов ухудшается работа иммунной системы, что увеличивает риск развития других, не менее серьезных заболеваний.
Основным направлением лечения является восстановление водно-солевого баланса. Часто детей госпитализируют с подобным диагнозом, так как их организм с трудом справляется с инфекцией. Также применяются специальные диеты, включающие продукты, способствующие улучшению перистальтики кишечника.
Чтобы снизить вероятность заражения бактериями и вирусами, важно следить за тем, чтобы ребенок употреблял только кипяченую воду и всегда мыл руки перед едой.
Необходимо тщательно мыть фрукты, ягоды и овощи, так как именно через них в организм ребенка могут попасть бактерии. Не стоит пренебрегать медицинской помощью, поскольку инфекционная диарея у детей развивается быстрее, чем у взрослых.
Диарея вирусного происхождения вызывает множество обсуждений среди людей, сталкивающихся с этой проблемой. Многие отмечают, что симптомы, такие как частые и водянистые стулы, сопровождаются общей слабостью и дискомфортом в животе. Важно отметить, что вирусная диарея часто передается через загрязненные продукты или воду, что делает профилактику особенно актуальной. Люди делятся опытом о том, как они справлялись с недомоганием: кто-то предпочитает пить много жидкости, чтобы избежать обезвоживания, другие используют специальные препараты для облегчения симптомов. В социальных сетях можно встретить советы по диете, где рекомендуются легкие блюда и избегание молочных продуктов. Несмотря на неприятные ощущения, большинство людей уверены, что вирусная диарея проходит самостоятельно в течение нескольких дней, и главное — не забывать о гигиене и заботе о своем здоровье.

Лечение
Вирусная диарея у детей и взрослых — это распространенное заболевание, с которым врачи знакомы и имеют эффективные методы лечения. В первую очередь они рекомендуют провести промывание желудка. Эта простая процедура помогает удалить из организма патогенные микроорганизмы и токсины.
Промывание осуществляется с использованием раствора гидрокарбоната натрия (0,5%) или обычной воды. Для этого врачи применяют зонд с воронкой на конце, который функционирует по принципу сифона, поднимаясь и опускаясь.
Какие другие методы лечения инфекционной диареи считаются наиболее действенными?
- В дополнение к промыванию, врачи рекомендуют пероральную гидратацию с использованием специального раствора, богатого электролитами и микроэлементами, особенно калием и кальцием.
- Затем назначаются препараты, такие как «Регидрон» и «Трисоль», чтобы предотвратить обезвоживание.
- При вирусной диарее могут быть рекомендованы полиферментные препараты, например, «Мезим Форте» или «Панкреатин».
- Для восстановления микрофлоры используются препараты, такие как «Бифиформ» и «Лактобактерин».
- Обязательно назначается диета, так как из-за инфекции желудок не может функционировать в обычном режиме и не способен переваривать тяжелую пищу.
Важно помнить, что антибиотики не следует использовать при лечении, так как это может негативно сказаться на состоянии пациента. Диеты, медикаменты и растворы для восстановления водно-солевого баланса — все это необходимо учитывать, так как эти меры способствуют улучшению состояния.
После перенесенного ротавируса рекомендуется в течение нескольких недель придерживаться специальной диеты, поскольку восстановление работы ЖКТ происходит не мгновенно.
Если речь идет о лечении детей, то многие медикаменты могут быть противопоказаны. В таких случаях врачам часто приходится прибегать к госпитализации, а острые формы заболевания требуют регулярного наблюдения в течение следующих шести месяцев. Лечение беременных женщин также усложняется, так как им нельзя принимать большинство лекарств.
Когда болезнь начинает отступать, человек может заметить это по уменьшению неприятных симптомов. Боль в животе проходит, каловые массы становятся более плотными, а общая слабость исчезает. Однако не стоит недооценивать инфекционные заболевания, так как недостаточное лечение может привести к рецидиву.
Вирусная диарея возникает довольно часто, и таким образом организм сигнализирует о наличии проблем. Чем быстрее пациент обратится к врачу, тем выше вероятность успешного устранения болезнетворной микрофлоры без негативных последствий.
Вопрос-ответ

Каковы основные симптомы вирусной диареи?
Основные симптомы вирусной диареи включают частые водянистые стулы, боли в животе, тошноту, рвоту и иногда лихорадку. Эти симптомы могут варьироваться по интенсивности и продолжительности в зависимости от конкретного вируса и состояния здоровья пациента.
Как можно предотвратить вирусную диарею?
Для предотвращения вирусной диареи рекомендуется соблюдать правила личной гигиены, такие как регулярное мытье рук с мылом, особенно перед едой и после посещения туалета. Также важно избегать употребления некипяченой воды и пищи, которая может быть загрязнена вирусами.
Когда следует обратиться к врачу при вирусной диарее?
Обратиться к врачу следует, если диарея продолжается более двух дней, сопровождается высокой температурой, сильной болью в животе, признаками обезвоживания (сухость во рту, уменьшение мочеиспускания) или если у пациента есть ослабленный иммунитет или другие серьезные заболевания.
Советы
СОВЕТ №1
При вирусной диарее важно поддерживать водный баланс. Убедитесь, что вы пьете достаточно жидкости, чтобы избежать обезвоживания. Подходят вода, бульоны и специальные растворы для регидратации.
СОВЕТ №2
Избегайте тяжелой и жирной пищи. В первые дни болезни лучше придерживаться легкой диеты, состоящей из риса, бананов, яблочного пюре и тостов, чтобы не нагружать желудок.
СОВЕТ №3
Обратите внимание на гигиену. Часто мойте руки с мылом, особенно после посещения туалета и перед едой, чтобы предотвратить распространение вируса.
СОВЕТ №4
Если симптомы не проходят в течение нескольких дней или ухудшаются, обязательно обратитесь к врачу. Это поможет исключить другие возможные причины диареи и получить необходимое лечение.